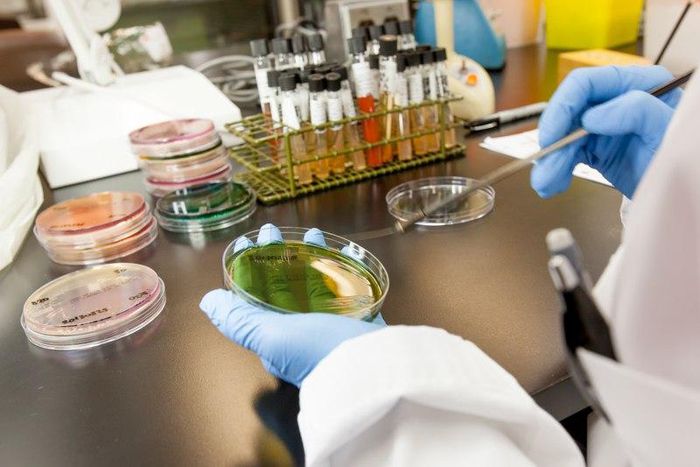
___4935104___https:______static.pulse.com.gh___webservice___escenic___binary___4935104___2016___4___19___11___lab

GABMLS asks Health Ministry to push for National Health Laboratory Policy
)
Chairman of the Editorial and Publicity Committee of the Association, Michael Adu Gyamfi said the policy, when successfully passed, would help the association manage medical laboratories across the country effectively.
The Center for Disease Control-USAID assisted the Association to draft the policy that sought to look at the management and independence of the laboratories.
Gyamfi said the Association was worried that the well captured document it put up with the help of the Health Ministry did not see the light of day due to some pressure of other groups.
The Association has also appealed to the Health Ministry to ensure that a Legislative Instrument is enacted to back the Legislation of the Laboratories since the act of Parliament was passed without an instrument backing it.
Gyamfi also appealed to the Fair Wages and Salaries Commission to place Biomedical Scientists who are Diploma holders on the Single Spine Pay policy since they are at par with nurses who are equally Diploma holders.


)
)
)
)
,fit(112:112))
)